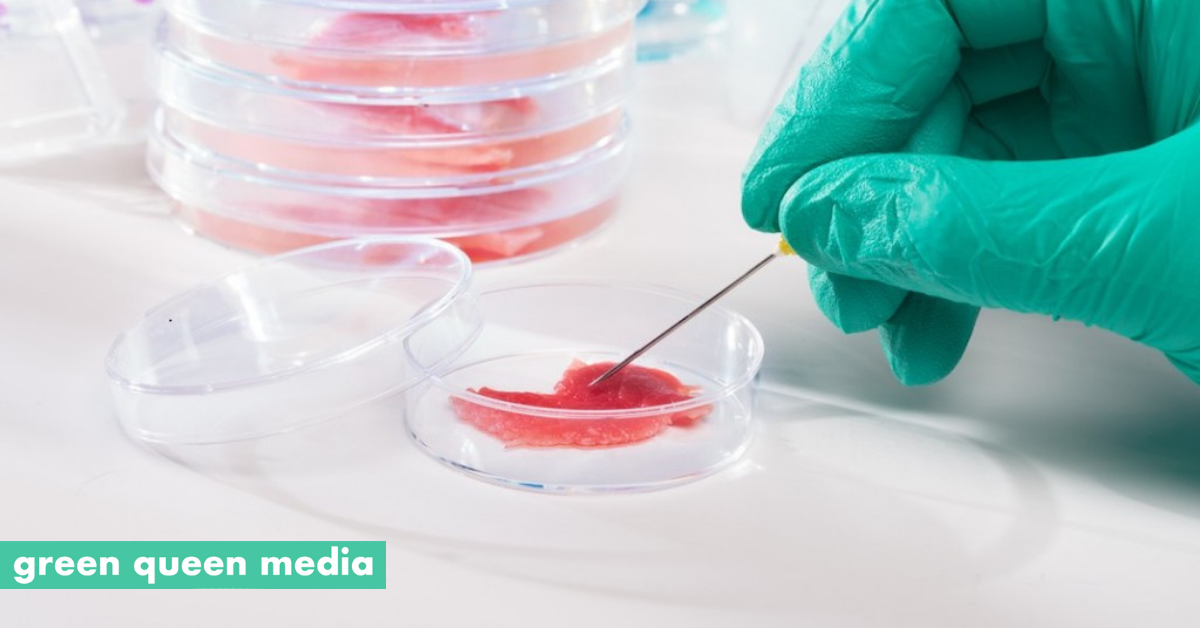

The six proteins were purified by Ni-chelating affinity chromatography (Figure 2 A), and protein-protein affinity was measured by biolayer interferometry 23 - 26, in which the obtained values reflect the amount of. Loop regions of the mofit are highly diversed in lenght among proteins. Comparison of these structures will be valuable for improving structure-function studies of ligand-gated ion channel receptors, including signal transduction, homology modeling, and drug design.ĭivision of Molecular Carcinogenesis, Netherlands Cancer Institute, Plesmanlaan 121, 1066 CX Amsterdam, The Netherlands.Abstract: Method of culturing embryonic stem (ES) cells of avian origin includes the steps of: a) suspending ES cells originating from the blastoderm disk of fertilized un-incubated avian egg(s) in a basal culture medium supplemented with: insulin-like growth factor-1 (IGF-1) and ciliary neurotrophic factor (CNTF) and animal serum and, optionally, at least one growth factor selected from among interleukin 6 (Il-6), interleukin 6 receptor (Il-6R), stem cell factor (SCF), fibroblast growth factor (FGF), leukemia inhibitory factor (LIF), interleukin 11 (Il-11), oncostatin and/or cardiotrophin b) seeding the suspension of ES cells obtained in step a) on a layer of feeder cells and further culturing the ES cells for at least 2 to 10 passages c) optionally, removing at least one growth factor selected from among SCF, FGF, Il-6, Il-6R, LIF, oncostatin, cardiotrophin and Il-11 from the culture medium and d) further culturing the ES cells in the medium of step c) on a layer of feeder cells. Furthermore, cargo proteins spontaneously covalently attach to the protein scaffolds in vitro. To synthesize the protein scaffold, three pairs of interacting proteins from E.

Structural, pharmacological and mutational analysis of both AChBPs shows how 3 amino acid changes in the binding site contribute to a 5-10-fold difference in affinity for nicotinic ligands. These include rigid body movements of loops that are close to the transmembrane interface in the receptors and changes in the intermonomer contacts, which alter the pentamer stability drastically. In this paper, we explore the possibility of using deep learning techniques to perform the task of predicting amino acids in partially sequenced proteins by two phases. Here we present the crystal structure of a remote homolog, AChBP from Bulinus truncatus, which reveals both the conserved structural scaffold and the sites of variation in this receptor family. De novo protein sequencing using top-down and bottom-up tandem mass spectrometry suffers from the problem of producing only partial sequences of target proteins, namely scaffold. The crystal structure of acetylcholine-binding protein (AChBP) from the mollusk Lymnaea stagnalis is the established model for the ligand binding domains of the ligand-gated ion channel family, which includes nicotinic acetylcholine, 5-hydroxytryptamine (5-HT3), gamma-aminobutyric acid (GABA), types A and C, and glycine receptors. Bioinformatics analysis allowed the peptides to be matched to the deduced protein sequences from EST databases and allowed functional assignment (e.g. Textured soy protein scaffolds enable the generation of three-dimensional bovine skeletal muscle tissue for cell-based meat, Nature Food (2020).DOI: 10.1038. 1), we have inverted deep learning structure prediction. Diversity, Equity, Inclusion, and Access On the protein design side, encouraged by the high accuracy of RoseTTAFold for predicting structures of de-novo-designed proteins (Fig. Thus, these proteins provide the connection between the organic (scaffolds) and inorganic (calcium carbonate crystals), form the intercrystalline organic.Citation, Usage, Privacy Policies, Logo.by forming dynamic scaffolds and templates (Tyszka et al., 2019). By combining robust gene engineering and phage display techniques, libraries with sufficient diversity could be established for target binding scaffold selection. Biologically Interesting Molecule Reference Dictionary (BIRD) The former is a calcium-binding protein with the SMP-related EF-hand domain that is. In mammals, MAPK scaffold protein KSR1 (Kinase Suppressor of Ras 1) is constitutively associated with MEK1/2 (two highly homologous MAPKKs) and retained in the cytosol through the interaction with 14-3-3 protein in resting cells (Figure 1 B). Protein scaffolds are small monomeric proteins with stable tertiary structures and mutable residues, which emerged in the 1990s. As hubs for eukaryotic cell signaling, scaffold proteins are attractive targets for engineering and manipulating signaling circuits.


 0 kommentar(er)
0 kommentar(er)
